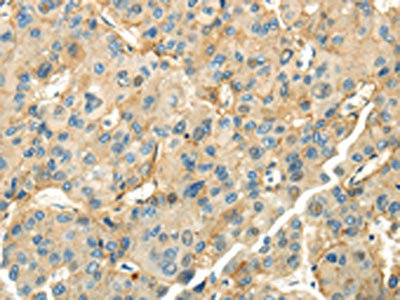

CD70 Antibody
-
中文名稱:CD70兔多克隆抗體
-
貨號:CSB-PA615999
-
規(guī)格:¥1100
-
圖片:
-
The image on the left is immunohistochemistry of paraffin-embedded Human liver cancer tissue using CSB-PA615999(CD70 Antibody) at dilution 1/35, on the right is treated with synthetic peptide. (Original magnification: ×200)
-
The image on the left is immunohistochemistry of paraffin-embedded Human thyroid cancer tissue using CSB-PA615999(CD70 Antibody) at dilution 1/35, on the right is treated with synthetic peptide. (Original magnification: ×200)
-
-
其他:
產(chǎn)品詳情
-
Uniprot No.:
-
基因名:
-
別名:CD 27L antibody; CD 70 antibody; CD27 L antibody; CD27 LG antibody; CD27 ligand antibody; CD27-L antibody; CD27L antibody; CD27LG antibody; CD70 antibody; CD70 antigen antibody; CD70 molecule antibody; CD70_HUMAN antibody; Ki 24 antigen antibody; Ki24 antigen antibody; Surface antigen CD70 antibody; TNFSF 7 antibody; TNFSF7 antibody; Tumor necrosis factor (ligand) superfamily, member 7 antibody; Tumor necrosis factor ligand superfamily member 7 antibody
-
宿主:Rabbit
-
反應種屬:Human
-
免疫原:Synthetic peptide of Human CD70
-
免疫原種屬:Homo sapiens (Human)
-
標記方式:Non-conjugated
-
抗體亞型:IgG
-
純化方式:Antigen affinity purification
-
濃度:It differs from different batches. Please contact us to confirm it.
-
保存緩沖液:-20°C, pH7.4 PBS, 0.05% NaN3, 40% Glycerol
-
產(chǎn)品提供形式:Liquid
-
應用范圍:ELISA,IHC
-
推薦稀釋比:
Application Recommended Dilution ELISA 1:2000-1:5000 IHC 1:25-1:100 -
Protocols:
-
儲存條件:Upon receipt, store at -20°C or -80°C. Avoid repeated freeze.
-
貨期:Basically, we can dispatch the products out in 1-3 working days after receiving your orders. Delivery time maybe differs from different purchasing way or location, please kindly consult your local distributors for specific delivery time.
-
用途:For Research Use Only. Not for use in diagnostic or therapeutic procedures.
相關產(chǎn)品
靶點詳情
-
功能:Cytokine which is the ligand for CD27. The CD70-CD27 pathway plays an important role in the generation and maintenance of T cell immunity, in particular during antiviral responses. Upon CD27 binding, induces the proliferation of costimulated T-cells and enhances the generation of cytolytic T-cells.
-
基因功能參考文獻:
- This dose-escalation phase I trial provides evidence of good tolerability of ARGX-110, pharmacokinetics, and preliminary antitumor activity at all dose levels in generally heavily pretreated patients with advanced CD70-positive malignancies PMID: 28765328
- Results show that CD70 promoter region methylation and expression are regulated by MBD4. Indeed, the study shows that downregulation of MBD4 contributed to overexpression and hypomethylation of the CD70 gene in CD4+ T cells from patients from systemic lupus erythematosus. PMID: 29018507
- CD70 mitigates atherosclerosis at least in part by modulating macrophage function. PMID: 27786334
- This study demonstrated that Expression of CD70 (CD27L) Is Associated With Epithelioid and Sarcomatous Features in IDH-Wild-Type Glioblastoma. PMID: 28789475
- CD27 is engaged by CD70 cross-presented by other AML blasts or stem/progenitor cells in a paracrine manner. PMID: 28031480
- human CD70-CD27 interactions therefore play a nonredundant role in T and B cell-mediated immunity, especially for protection against EBV and humoral immunity. PMID: 28011864
- These data demonstrate the important role of the CD70/CD27 axis in immune responses in HTLV-1 carriers and ATL patients. PMID: 26077361
- CD70: An emerging target in cancer immunotherapy PMID: 26213107
- Both monomeric and trimeric forms of CD70 were detected in tumour cell membrane fractions, whereas cytoplasmic fractions contained almost exclusively monomeric CD70 PMID: 26671750
- CD70 is overexpressed in systemic lupus erythematosus CD4+ T cells, but expression is not linked to the typical clinical and serological parameters associated with the disease. PMID: 24238281
- CD70-blocking of alphaDC1s from both controls and patients with chronic lymphocytic leukaemia had a negative influence on the production of both IL-12p70 and the Th1 cytokine IFN-gamma. PMID: 24684541
- CD70 acts as a functional receptor binding to soluble CD27, resulting in lymphoma progression and that immunotherapy using anti-CD70 antibody may be a potential candidate for treatment for NNKTL. PMID: 23206232
- The mean expression of CD70 was almost twice as high in renal cell carcinoma relative to normal kidney tissue PMID: 22401771
- Regulation of Langerhans cell CD70 expression is important in enhancing immunity against cutaneous epithelial pathogens and cancer. PMID: 22377764
- Findings suggest that demethylation of CD70 promoter region contributes to the overexpression of CD70 in CD4+ T cells and may contribute to autoimmune response in systemic sclerosis (SSc). PMID: 22306512
- These findings indicate that aberrant histone modifications within the TNFSF7 promoter may contribute to the development of lupus by increasing CD70 expression in CD4(+) T cells. PMID: 21865261
- CD70 and CD11a facilitate the survival of T and B lymphocytes and indirectly enhance the destruction of platelets in immune thrombocytopenia. PMID: 21541792
- data indicate that the virus-induced selective upregulation of CD70 by Langerhans cells is the critical feature that enhances their capacity to induce effector CD8+ T cell responses compared with virus-primed dermal dendritic cells that lack CD70 PMID: 21880979
- concluded DNA methyltransferases(DNMTs) functioned as demethylases as MBD2, while increased DNMTs and MBD2 may cause demethylation and over expression of CD70 in CD4(+) T cells, potentially contributing to the pathogenesis of immune thrombocytopenia PMID: 21550117
- Th1 cell-specific CD70 expression may be involved in an amplification loop for polarized Th1-type immune responses through T cell-T cell interactions. PMID: 21490618
- Stimulation of T cells expressing CD70-specific chimeric antigen receptors resulted in CD27 costimulation and recognition of CD70-positive tumor cell lines and primary tumor cells, as shown by IFN-gamma and IL-2 secretion and by tumor cell killing. PMID: 21304103
- RFX1 recruits SUV39H1 to the promoter regions of the CD11a and CD70 genes in CD4(+) T cells, thereby regulating local H3K9 tri-methylation levels. PMID: 21192791
- In this review, CD27 and CD70 constitute a unique pair ligand and receptor pair which can activate innate and adaptive immunity as well as regulate immunity versus tolerance. PMID: 20699361
- CD70 expression was significantly elevated and correlated with a decrease in CD70 promoter methylation in T4 lymphocytes from Sjogren's syndrome patients as compared to levels in controls. PMID: 20724115
- Epigenetic silencing of the TNFSF7 gene via hypermethylation of its proximal region may allow the benign and invasive MCF10 variants to escape immune surveillance. PMID: 20119871
- the CD70-CD27 interaction may play an important role in inducing effective immune responses in dendritic cell-based immunotherapy. PMID: 20201989
- CD70 is an important factor in the regulation of B-cell growth and differentiation by plasmacytoid dendritic cells. PMID: 20139096
- Data confirm previous observations of higher expression of CD70 in CD4+ T cells from patients with SLE, and suggest that increased Fyn protein content in CD4+ T cells can be associated with high SLE disease activity. PMID: 19955046
- Identification of CD70-mediated apoptosis of immune effector cells as a novel immune escape pathway of human glioblastoma PMID: 11980654
- intragraft gene expression is not a risk factor for acute cardiac allograft rejection PMID: 12009595
- Systemic lupus erythematosus T cells and T cells treated with DNA methyltransferase inhibitors and ERK pathway inhibitors overexpress CD70. PMID: 15188362
- Immunocytochemical analysis demonstrated that binding of an anti-CD70 antibody to CD70(TNFSF7), endogenously expressed on the surface of A498 and 786-O cell lines resulted in the rapid internalisation of the antibody-receptor complex. PMID: 16892042
- Apoptosis mediated by exposure to the CD70 secreted by tumor cells may contribute to the failure of renal cell carcinoma patients to develop an effective lymphocyte-mediated antitumor response PMID: 17132225
- reveal a novel role for non-Hodgkin lymphoma B cells in the development of intratumoral regulatory T cells PMID: 17615291
- CD27-CD70 interactions in the pathogenesis of Waldenstrom macroglobulinemia. PMID: 18216294
- CD70 gene was upregulated more than 1,000-fold and the enhanced expression of the CD70 molecule was confirmed by laser flow cytometry for various HTLV-1-carrying T-cell lines and primary CD4(+) T cells isolated from acute-type ATL patients. PMID: 18256142
- Dendritic cells matured in the presence of PGE(2) induced the expression of OX40, OX40L, and CD70 on T cells facilitating T-cell/T-cell interaction that warrant long-lasting costimulation. PMID: 19029446
- CD70 not only contributes to the activation of cytotoxic T cells in B cell precursor acute lymphoblastic leukemia but is a critical signal during the expansion phase of the cytotoxic T cell response. PMID: 19109206
- Constitutive expression of CD70 transgene is sufficient to deregulate the CD8 T cell differentiation pathway of acute infection reminiscent of events in chronic infection. PMID: 19380782
- Data showed that the CD70, perforin and KIR2DL4 promoters are demethylated in CD4(+)CD28(-) T cells, and that DNA methyltransferase 1 (Dnmt1) and Dnmt3a levels are decreased in this subset. PMID: 19394279
顯示更多
收起更多
-
亞細胞定位:Membrane; Single-pass type II membrane protein.
-
蛋白家族:Tumor necrosis factor family
-
數(shù)據(jù)庫鏈接:
Most popular with customers
-
-
YWHAB Recombinant Monoclonal Antibody
Applications: ELISA, WB, IHC, IF, FC
Species Reactivity: Human, Mouse, Rat
-
-
-
-
-
-